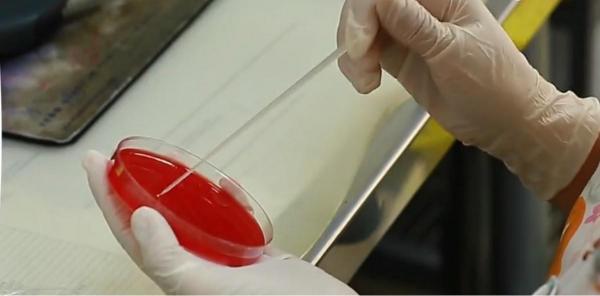
Mâncare contaminată cu stafilococ, la două săli de evenimente din Alba: 20 de persoane au ajuns cu toxiinfecţie la spital

Incendiu devastator în Alba: Limbile de foc au mistuit acoperişurile a două case și au făcut scrum o maşină
Incendiu devastator în Alba: Limbile de foc au mistuit acoperişurile a două case și au făcut scrum o maşinăUn incendiu devastator a mistuit acoperişurile a două case şi a făcut scrum o maşină aflată într-un garaj.
pe 21.03.2023 la 07:38
Bărbat de 43 de ani, amendat după ce a pulverizat "din greșeală" cu spray lacrimogen în Casa de Pensii din Alba
Bărbat de 43 de ani, amendat după ce a pulverizat "din greșeală" cu spray lacrimogen în Casa de Pensii din AlbaUn brăbat de 43 de ani a fost amendat, după ce ar fi pulverizat, "în mod accidental", spray lacrimogen...
pe 16.03.2023 la 15:36
Accident tras la indigo, pe o pârtie din Alba. O tânără de 18 ani s-a răsturnat cu ATV-ul în acelaşi loc unde, acum 3 săptămâni, o alta a fost grav rănită
Accident tras la indigo, pe o pârtie din Alba. O tânără de 18 ani s-a răsturnat cu ATV-ul în acelaşi loc unde, acum 3 săptămâni, o alta a fost grav rănităO tânără de 18 ani a fost preluată, sâmbătă, de salvamontiști, după un accident cu ATV-ul, pe pârtia...
pe 11.03.2023 la 15:15
Accident în Alba: fată de 16 ani, în stare gravă după ce o alta, de 15 ani, a furat mașina părinților și s-a răsturnat
Accident în Alba: fată de 16 ani, în stare gravă după ce o alta, de 15 ani, a furat mașina părinților și s-a răsturnatAccident în Alba. Două adolescente de 15, respectiv 16 ani au fost rănite, luni, fiind transportate la spital, după ce...
pe 20.02.2023 la 16:09
Cutia milei, "magnet" pentru tâlhari. Două biserici din Alba, prădate de hoţi
Cutia milei, "magnet" pentru tâlhari. Două biserici din Alba, prădate de hoţiDouă biserici din localitatea Şibot au fost prădate de hoţi în noaptea de sâmbătă spre duminică. Indivizii...
pe 20.02.2023 la 13:28
Tânără de 21 de ani, grav rănită într-un accident cu ATV-ul, pe o pârtie din Alba. A fost transportată cu elicopterul SMURD la Oradea
Tânără de 21 de ani, grav rănită într-un accident cu ATV-ul, pe o pârtie din Alba. A fost transportată cu elicopterul SMURD la OradeaUn incident nefericit s-a petrecut la finalul săptămânii, în judeţul Alba. Salvamontiştii anunţă că...
pe 12.02.2023 la 16:10
Tragedie în Apuseni. O tânără mămică a murit la trei zile după ce a născut. Fusese preluată de ambulanță împreună cu bebelușul ei
Tragedie în Apuseni. O tânără mămică a murit la trei zile după ce a născut. Fusese preluată de ambulanță împreună cu bebelușul eiTragedie într-o localitate izolată din Apuseni. O tânără în vârstă de 33 de ani din Scărișoara,...
pe 05.02.2023 la 13:36
Afacerea "nemuritoare" din care câțiva meșteri fac bani frumoși în Alba. Un singur produs costă 150 de lei
Afacerea "nemuritoare" din care câțiva meșteri fac bani frumoși în Alba. Un singur produs costă 150 de leiPe vremuri, pălăria era un simbol al societăţii şi era nelipsită din garderobă. Femei sau bărbaţi, cu toţii purtau...
pe 25.01.2023 la 17:01
Incendiu puternic pe A10, în Alba. Un camion care transporta deşeuri de carton a luat foc în mers
Incendiu puternic pe A10, în Alba. Un camion care transporta deşeuri de carton a luat foc în mersIncendiu puternic, seara trecută, pe Autostrada A 10, în judeţul Alba. Un camion care transporta deşeuri de carton s-a...
pe 24.01.2023 la 07:50
Un autocamion care transporta deşeuri de carton a fost cuprins de flăcări pe A10, la ieşirea din localitatea Delcea
Un autocamion care transporta deşeuri de carton a fost cuprins de flăcări pe A10, la ieşirea din localitatea DelceaUn autocamion care transporta deşeuri de carton a fost cuprins de flăcări în timp ce era pe autostrada A10, la ieşirea...
pe 23.01.2023 la 22:01
Un bărbat din Alba s-a împușcat în cap din greșeală, la o stână. Polițiștii l-au găsit fără suflare
Un bărbat din Alba s-a împușcat în cap din greșeală, la o stână. Polițiștii l-au găsit fără suflareUn bărbat, în vârstă de 34 de ani, din comuna Poșaga, județul Alba, s-a împușcat accidental în...
pe 14.01.2023 la 16:49
Un șofer de 19 ani a zburat cu BMW-ul pe acoperișul unei case, în Alba. "Doamne ferește! Uite unde o ajuns motorul!"
Un șofer de 19 ani a zburat cu BMW-ul pe acoperișul unei case, în Alba. "Doamne ferește! Uite unde o ajuns motorul!"Accident teribil, aseară, în judeţul Alba. O maşină a zburat, la propriu, de pe şosea, pe acoperişul unei case....
pe 05.01.2023 la 14:05
Patru persoane au fost rănite, după ce două maşini s-au ciocnit frontal, în Alba
Patru persoane au fost rănite, după ce două maşini s-au ciocnit frontal, în AlbaPatru persoane au fost rănite, duminică, după ce două maşini s-au ciocnit frontal în judeţul Alba, potrivit News.ro...
pe 18.12.2022 la 16:53
Secretul vinului românesc pe care îl bea şi Papa. Recolta uriaşă a adus la noi şi muncitori nepalezi: "E o mare diferenţă în România"
Secretul vinului românesc pe care îl bea şi Papa. Recolta uriaşă a adus la noi şi muncitori nepalezi: "E o mare diferenţă în România"Anul acesta pare să fie unul foarte bun pentru vinul de gheaţă. Extrem de apreciat inclusiv la Vatican, se face doar din...
pe 14.12.2022 la 20:37
Român căutat de autorităţile din Polonia pentru furt, prins de poliţişti în Alba
Român căutat de autorităţile din Polonia pentru furt, prins de poliţişti în AlbaUn bărbat din comuna Mihalţ, căutat de autorităţile din Polonia pentru furt, a fost prins de poliţiştii din Alba. Avea emis...
pe 13.12.2022 la 12:02
Femeie din Alba, reținută după ce a spart geamul unei secții de poliție. S-ar fi enervat după ce concubinul a sunat la 112
Femeie din Alba, reținută după ce a spart geamul unei secții de poliție. S-ar fi enervat după ce concubinul a sunat la 112O femeie din Alba Iulia a fost reţinută după ce, pe fondul unui conflict cu concubinul său, a aruncat, duminică, cu o piatră...
pe 11.12.2022 la 21:11
Incendiu de proporţii la o fabrică din Sebeş. Zeci de pompieri s-au luptat cu focul timp de ore întregi
Incendiu de proporţii la o fabrică din Sebeş. Zeci de pompieri s-au luptat cu focul timp de ore întregiUn incendiu de proporţii a avut loc noaptea trecută la o fabrică de prelucrare a lemnului din Sebeş, judeţul Alba. Din...
pe 06.12.2022 la 13:26
O persoană din Alba a suferit arsuri pe 40% din corp, după ce casa i-a fost cuprinsă de flăcări
O persoană din Alba a suferit arsuri pe 40% din corp, după ce casa i-a fost cuprinsă de flăcăriO persoană a suferit arsuri de gradul 2 şi 3 pe aproximativ 40% din suprafaţa corpului, în urma unui incendiu care a...
pe 26.11.2022 la 18:20
Detalii înfiorătoare din casa groazei din Alba, unde o copilă a fost violată, timp de doi ani, de iubitul mamei, dar şi de un prieten
Detalii înfiorătoare din casa groazei din Alba, unde o copilă a fost violată, timp de doi ani, de iubitul mamei, dar şi de un prietenDestin cumplit pentru o fetiţă de 9 ani din judeţul Alba. Copila a fost violată, timp de doi ani, de iubitul mamei, dar şi de...
pe 25.11.2022 la 13:30
Copilă de 9 ani din Alba, violată de iubitul mamei şi de prietenul acestuia, în repetate rânduri. Femeia a urmărit scenele cumplite
Copilă de 9 ani din Alba, violată de iubitul mamei şi de prietenul acestuia, în repetate rânduri. Femeia a urmărit scenele cumpliteSituaţie halucinantă în Alba! O copilă de 9 ani a fost violată, în repetate rânduri, de partenerul mamei sale...
pe 24.11.2022 la 11:50
Scene de coşmar pe DN 7, la Vinţu de Jos. Doi oameni au murit pe loc, după ce maşina în care se aflau a fost spulberată de un TIR încărcat cu cereale
Scene de coşmar pe DN 7, la Vinţu de Jos. Doi oameni au murit pe loc, după ce maşina în care se aflau a fost spulberată de un TIR încărcat cu cerealeUn accident cumplit s-a petrecut noaptea trecută în Alba, pe raza localităţii Vinţu de Jos. Două persoane şi-au pierdut...
pe 23.11.2022 la 07:33
Viaţă curmată la doar 18 ani, în drum spre Blaj. Un tânăr a murit, singur în maşină, după ce s-a izbit de un copac
Viaţă curmată la doar 18 ani, în drum spre Blaj. Un tânăr a murit, singur în maşină, după ce s-a izbit de un copacUn tânăr de 18 ani a murit, sâmbătă, într-un accident pe DN 14B, între Blaj şi Crăciunelu de Jos,...
pe 19.11.2022 la 17:20
Aplicaţia care semnalizează problemele de mediu din Alba: "Trebuie să începem să conştientizăm cât de mare e problema"
Aplicaţia care semnalizează problemele de mediu din Alba: "Trebuie să începem să conştientizăm cât de mare e problema"Un grup de cercetători din cadrul Universităţii Babeş-Bolyai, din Cluj-Napoca, a lansat o aplicaţie care îşi propune...
pe 16.11.2022 la 08:25
Casă înghiţită de flăcări. Focul s-a propagat cu o asemenea repeziciune încât nu a mai putut fi nimic salvat
Casă înghiţită de flăcări. Focul s-a propagat cu o asemenea repeziciune încât nu a mai putut fi nimic salvatIncendiu puternic, în Aiudul de Sus, judeţul Alba. O casă a fost înghiţită de flăcări la lăsarea serii, iar...
pe 14.11.2022 la 07:21
O tânără din Alba a fost luată dintr-o parcare pentru a fi măritată cu forţa. Femeia credea că merge să ia masa la un restaurant
O tânără din Alba a fost luată dintr-o parcare pentru a fi măritată cu forţa. Femeia credea că merge să ia masa la un restaurantCinci persoane care au răpit o tânără din Alba și au dus-o până în județul Timiș au fost...
pe 13.11.2022 la 14:03
Morminte marcate cu roşu în Alba, dacă nu a fost plătită taxa de 165 de lei. Reacţiile rudelor când au văzut situaţia
Morminte marcate cu roşu în Alba, dacă nu a fost plătită taxa de 165 de lei. Reacţiile rudelor când au văzut situaţiaDecizie revoltătoare la Alba Iulia, unde administraţia cimitirelor a marcat cu vopsea roşie crucile de pe locurile de veci care...
pe 07.11.2022 la 20:59
"În câteva secunde, i-au tăiat funia". Doi polițiști din Alba au salvat viața unui bărbat care voia să se spânzure
"În câteva secunde, i-au tăiat funia". Doi polițiști din Alba au salvat viața unui bărbat care voia să se spânzureDoi polițiști din Alba, agent-șef principal Gabriel Neagu și agent Alexandru Vulturar, au salvat viața unui bărbat în...
pe 29.10.2022 la 12:35
Răsturnare de situație în cazul femeii din Alba, suspectă de botulism. Institutul Cantacuzino nu a confirmat boala
Răsturnare de situație în cazul femeii din Alba, suspectă de botulism. Institutul Cantacuzino nu a confirmat boalaRăsturnare de situație în cazul femeii din Alba Iulia, suspectată de botulism după ce ar fi consumat o conservă...
pe 25.10.2022 la 11:00
Un antrenor din Abrud, coordonatorul unui bordel cu minore. Printre clienţi, un fost primar şi un fost poliţist
Un antrenor din Abrud, coordonatorul unui bordel cu minore. Printre clienţi, un fost primar şi un fost poliţistCaz şocant la Abrud, judeţul Alba! Fostul primar al oraşului, un fost poliţist şi un antrenor sunt cercetaţi într-un...
pe 20.10.2022 la 08:00
"Este primul caz în istoria recentă a județului". O femeie din Alba, suspectă de botulism după ce a mâncat pește dintr-o conservă
"Este primul caz în istoria recentă a județului". O femeie din Alba, suspectă de botulism după ce a mâncat pește dintr-o conservăO femeie din Alba a ajuns la spital cu suspiciune de botulism , după ce a mâncat o salată făcută cu peştele dintr-o...
pe 20.10.2022 la 07:36
Tânăr, cercetat penal după ce a rănit un câine cu o armă cu aer comprimat. Avea un întreg arsenal acasă
Tânăr, cercetat penal după ce a rănit un câine cu o armă cu aer comprimat. Avea un întreg arsenal acasăUn tânăr dintr-o comună din Alba este cercetat pentru nerespectarea regimului armelor şi muniţiilor, uz de armă fără...
pe 17.10.2022 la 14:51
Sute de localnici evacuați din cauza fisurii din barajul de la Roșia Montană. Inginerii au nevoie de trei zile pentru a goli lacul
Sute de localnici evacuați din cauza fisurii din barajul de la Roșia Montană. Inginerii au nevoie de trei zile pentru a goli laculSute de localnici din Roşia Montană au fost evacuaţi după ce în apropierea barajului unui lac aflat în amonte a...
pe 02.10.2022 la 19:58
Descoperirea întâmplătoare făcută de un tânăr de 27 de ani într-o pădure din Alba a dus la găsirea unei adevărate comori
Descoperirea întâmplătoare făcută de un tânăr de 27 de ani într-o pădure din Alba a dus la găsirea unei adevărate comoriDescoperirea făcută de un tânăr de 27 de ani în urmă cu câteva luni a dus la găsirea unei adevărate comori.
pe 22.09.2022 la 15:26
Zeci de nuntași au ajuns la spital cu Salmonella, în Alba, după ce au mâncat eclerele oferite de miri la pachet
Zeci de nuntași au ajuns la spital cu Salmonella, în Alba, după ce au mâncat eclerele oferite de miri la pachetDe la nuntă, la spital. De acest traseu au avut parte zeci de persoane pentru care o petrecere de nuntă s-a transformat...
pe 09.09.2022 la 09:17
"Tot satul i-a plâns. E un gol care rămâne până îi astupă pământul". Familia din Alba care şi-a găsit sfâşitul pe Valea Oltului, condusă pe ultimul drum
"Tot satul i-a plâns. E un gol care rămâne până îi astupă pământul". Familia din Alba care şi-a găsit sfâşitul pe Valea Oltului, condusă pe ultimul drumpe 26.08.2022 la 10:17

Urs filmat alergând în faţa unei maşini, pe o şosea din Alba. Şoferul s-a trezit cu animalul în bătaia farurilor
Urs filmat alergând în faţa unei maşini, pe o şosea din Alba. Şoferul s-a trezit cu animalul în bătaia farurilorImagini incredibile surprinse în comuna Pianu din Alba, unde un urs a fost filmat cum aleargă în faţa unei maşini.
pe 17.08.2022 la 14:30
Lecție de viață: Ioan a găsit un portofel cu bani pe jos, însă nu s-a atins de niciun leu. A mers cu el direct la Poliție
Lecție de viață: Ioan a găsit un portofel cu bani pe jos, însă nu s-a atins de niciun leu. A mers cu el direct la PolițieIoan Furdui, un bărbat în vârstă de 45 de ani din județul Alba, a dat dovadă de un caracter ireproșabil după ce a...
pe 27.07.2022 la 15:44
Acoperişul unui bloc s-a desprins din cauza rafalelor puternice, în Alba. Zece maşini au fost serios avariate
Acoperişul unui bloc s-a desprins din cauza rafalelor puternice, în Alba. Zece maşini au fost serios avariateMai multe autoturisme au fost avariate duminică, după ce, în condiţiile unui vânt puternic, acoperişul unui bloc...
pe 24.07.2022 la 17:15
O tânără din Alba, găsită dezbrăcată într-un grajd. Femeia ar fi fugit de un bărbat care a încercat să o violeze
O tânără din Alba, găsită dezbrăcată într-un grajd. Femeia ar fi fugit de un bărbat care a încercat să o violezeO tânără din Alba a fost găsită dezbrăcată într-un grajd, după ce a fugit de un bărbat care a încercat...
pe 13.07.2022 la 14:00
Mașină de la Poliția Autostrăzi, lovită de TIR pe A10, între Alba Iulia și Sebeș. Agenții interveneau la un alt accident
Mașină de la Poliția Autostrăzi, lovită de TIR pe A10, între Alba Iulia și Sebeș. Agenții interveneau la un alt accidentPatru persoane, între care un copil, au ajuns la spital, în această dimineață, în urma unui grav accident...
pe 08.07.2022 la 15:08
Un băiat de 15 ani şi-a riscat viaţa pentru un selfie, electrocutat lângă calea ferată. Medicii nu l-au mai putut salva
Un băiat de 15 ani şi-a riscat viaţa pentru un selfie, electrocutat lângă calea ferată. Medicii nu l-au mai putut salvaUn băiat în vârstă de 15 ani din Alba-Iulia s-a electrocutat. Pompierii care au ajuns imediat la faţa locului...
pe 16.06.2022 la 16:58
Descoperire macabră în Alba. Bărbat, găsit spânzurat într-o magazie de pompierii care au venit să stingă incendiul care cuprinsese casa
Descoperire macabră în Alba. Bărbat, găsit spânzurat într-o magazie de pompierii care au venit să stingă incendiul care cuprinsese casaDescoperire macabră într-o gospodărie din Alba. Un bărbat a fost găsit spânzurat într-o anexă a casei sale....
pe 16.06.2022 la 09:12
Tragedie cumplită pentru o familie din Alba. Un copil de doar 5 ani s-a înecat în râul Cugir
Tragedie cumplită pentru o familie din Alba. Un copil de doar 5 ani s-a înecat în râul CugirTragedie cumplită pentru o întreagă familie din Alba, după ce copilul lor de 5 ani a pierit înecat în...
pe 13.06.2022 la 15:52
Afacere înfloritoare. Sătenii dintr-o comună din Alba au renunţat la porumb şi floarea soarelui şi cultiva trandafiri
Afacere înfloritoare. Sătenii dintr-o comună din Alba au renunţat la porumb şi floarea soarelui şi cultiva trandafiriTărâmul trandafirilor e în România, mai exact într-o comună din Alba. Sătenii de acolo au înlocuit...
pe 01.05.2022 la 08:00
O livadă de aluni, afacerea de succes a unui tânăr din Alba. A preluat ideea de la fratele său, stabilt în Italia
O livadă de aluni, afacerea de succes a unui tânăr din Alba. A preluat ideea de la fratele său, stabilt în ItaliaA pus bazele unei afaceri mai puţin obişnuite, dar care îi aduce an de an venituri peste medie. Un agricultor din judeţul...
pe 31.03.2022 la 17:50
O poştăriţă din Alba a furat 35.000 de lei din banii de pensii şi alocaţii. În 2020, femeia a candidat pentru un post de senator
O poştăriţă din Alba a furat 35.000 de lei din banii de pensii şi alocaţii. În 2020, femeia a candidat pentru un post de senatorO poştăriţă din Alba a fost reţinută după ce a furat banii de pensii şi alocaţii ale localnicilor. Chiar şi...
pe 18.02.2022 la 17:34
Un elev de clasa a IX-a din Alba a creat și lansat propriul său joc pe telefon. Robert şi-a uimit familia şi profesorii
Un elev de clasa a IX-a din Alba a creat și lansat propriul său joc pe telefon. Robert şi-a uimit familia şi profesoriiUn elev de clasa a IX-a din Alba a uimit pe toată lumea cu talentul şi ambiţia sa. Băiatul a creat şi lansat propriul său joc...
pe 10.02.2022 la 08:46
Furia apelor face ravagii în Apuseni, este cod roșu de inundații pe râul Arieș. Mesaj RO-Alert pentru populație
Furia apelor face ravagii în Apuseni, este cod roșu de inundații pe râul Arieș. Mesaj RO-Alert pentru populațieUn drum care duce către Poiana Sohodol, din judeţul Alba, a fost rupt de puhoaie, iar acum accesul în localitate se poate face...
pe 26.12.2021 la 07:45
Caz de trichineloză depistat la un porc tăiat într-o gospodărie din comuna Gârbova. Avertismentul medicilor veterinari
Caz de trichineloză depistat la un porc tăiat într-o gospodărie din comuna Gârbova. Avertismentul medicilor veterinariSuntem deja cu gândul la masa de Crăciun, dar mare atenţie la ce puneţi pe masă. A apărut primul caz de trichineloză la un...
pe 15.12.2021 la 14:25
Comuna cu cea mai mare rată de infectare din România este în Alba: aproape 30 la mia de locuitori
Comuna cu cea mai mare rată de infectare din România este în Alba: aproape 30 la mia de locuitoriComuna cu cea mai mare rată de infectare din România se află în județul Alba. Este vorba despre localitatea Ceru-Băcăinți,...
pe 03.12.2021 la 13:05